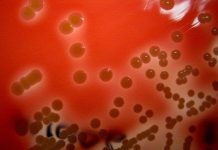
Vi khuẩn mới trong lỗ mũi sẽ đưa nhân loại vượt qua thời đại kháng kháng sinh Vi khuẩn mới trong lỗ mũi sẽ đưa nhân loại vượt qua thời đại kháng kháng sinh

Các nhà thực vật Viện Sinh học nhiệt đới thuộc Viện Hàn lâm Khoa học và Công nghệ Việt Nam và Cộng hòa Séc đã phát hiện và công bố một loài lan mới ở Khu Bảo tồn thiên nhiên Hòn Bà.
Loài lan này được đặt tên là Lan yersin (Cleisostoma yersinii J. Ponert & Vuong), theo tên của Bác sĩ Alexandre Yersin, người đã khám phá ra Hòn Bà và ông cũng là người từng sống và làm việc ở đây vào đầu thế kỷ 20.
Đặc điểm nhận dạng loài Cleisostoma lecongkietii Tich et Aver. (Ảnh: Viện Sinh học nhiệt đới).
Trước đó, vào tháng 9/2015, G.S Lenonid A. Veryanov và cộng sự cũng đã công bố một loài lan mới được phát hiện ở Bình Thuận trên tạp chí Taiwainia, tập 60, số 3 và đặt tên là Lan lê công kiệt (Cleisostoma lecongkietii Tich et Aver.). Các nhà nghiên cứu đã đối chiếu và so mẫu thì 2 loài lan này là giống nhau và cùng một loài, và khẳng định loài Lan yersin (C. yersinii) hiển nhiên là tên đồng danh (synonym) của loài Lan lê công kiệt (C. lecongkietii).
Loài Lan lê công kiệt (C. lecongkietii) được tìm thấy ở độ cao từ 600–800m so với mực nước biển (Aver et. al, 2015), trong khi đó loài Lan yersin (C. yersinii) được tìm thấy ở độ cao trên 1.500m tại Khu Bảo tồn thiên nhiên Hòn Bà, và đây cũng là vùng phân bố mới của loài lan này.
Lan yersin là tên đồng danh của Lan lê công kiệt. (Ảnh: Viện Sinh học nhiệt đới).
Được biết, đến nay các nhà thực vật Viện Sinh học nhiệt đới thuộc Viện Hàn lâm Khoa học và Công nghệ Việt Nam đã phát hiện và mô tả 4 loài mới về lan (kể cả loài Cleisostoma yersinii) là: Vanilla atropogon, Cordiglottis longipedicellata, Miguelia cruenta, Cleisostoma lecongkietii (Synonym: Cleisostmoa yersinii).
Theo khoahocphattrien